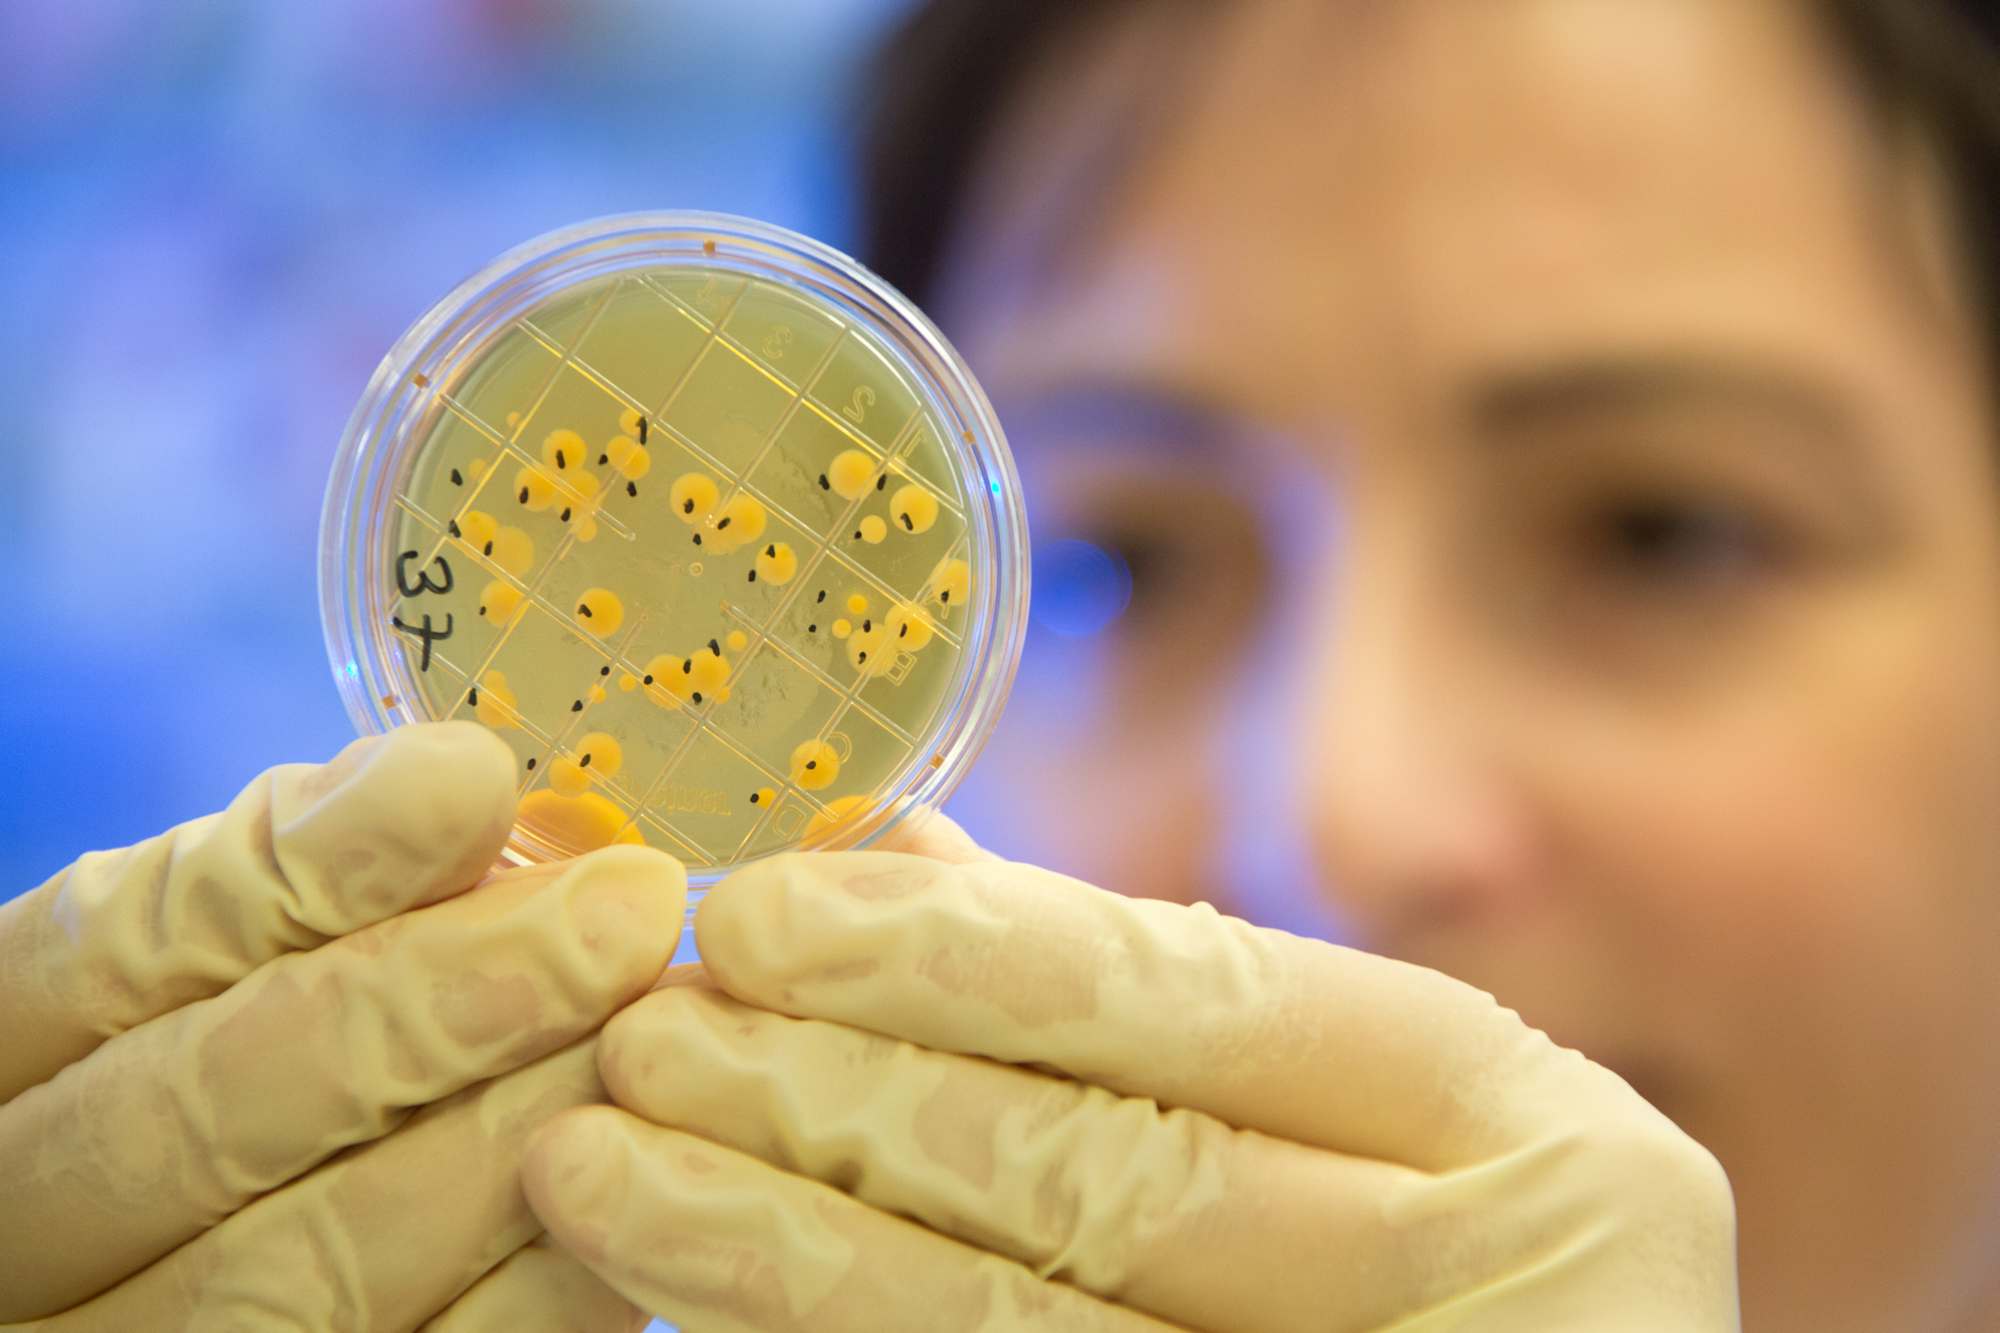

Für die Zukunft aufgestellt: Prüflabore von DITF und ITVP auf DIN EN ISO/IEC 17025:2018 umgestellt

Downloads
Ansprechpartnerin
Das Prüflabor Textiltechnik und Technische Textilien der Deutschen Institute für Textil- und Faserforschung (DITF) sowie das Prüflabor der ITV Denkendorf Produktservice GmbH (ITVP) wurden erfolgreich nach der aktuellen DIN EN ISO/IEC 17025:2018 „Allgemeine Anforderungen an die Kompetenz von Prüf- und Kalibrierlaboratorien“ akkreditiert. Das Prüflabor der DITF hat am 13. Oktober 2020 seine Akkreditierungsurkunde erhalten, die DITF-Tochter ITVP erhielt die Urkunde bereits am 31. August 2020.
Im Frühjahr dieses Jahres hatte die Deutsche Akkreditierungsstelle GmbH (DAkkS) beide Labore umfangreich begutachtet. Dabei wurde festgestellt, dass alle regulatorischen Anforderungen in den Bereichen Personal, Validität der Prüfergebnisse sowie dem Umfang mit Risiken und Chancen erfüllt und umgesetzt werden.
Die erfolgreiche Akkreditierung ist das Ergebnis eines ausführlichen Umstrukturierungsprozesses. „Beide Labore sind mit der Akkreditierung nach der neuen Norm bestens für die Zukunft gerüstet und können ihren Kunden weiterhin einen Service auf gewohnt hohem Niveau bieten“ freut sich Kathrin Thumm, die an den DITF und bei der ITVP für das Qualitätsmanagement verantwortlich ist.